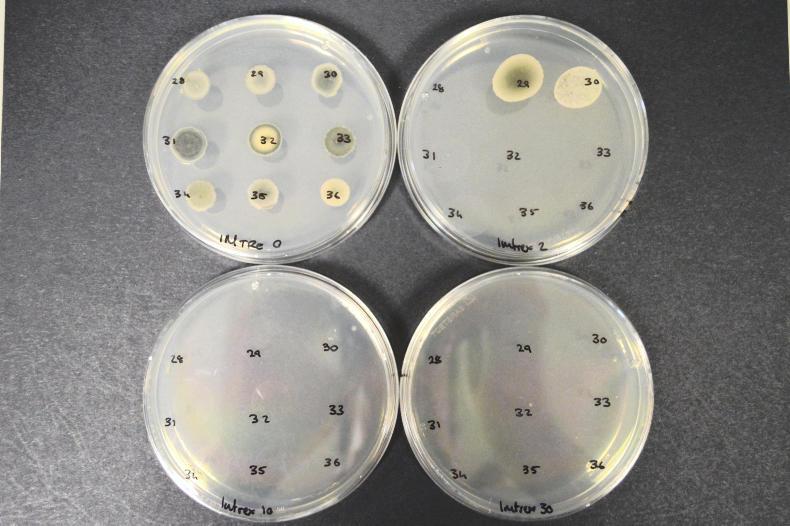

From the end of March through to mid-June every year, we become engaged in a battle between cereal diseases and our ability to control them. This battle takes place at the microscopic level and, in most instances, the scars of war remain unnoticed. Unfortunately, there will always be instances where these scars, in the form of diseased leaves, ears or grain, appear and result in reduced yields.
At research level, we must continue to examine what is happening if the battle is to be won and control of diseases achieved in future seasons.
Dissecting control failures
The first task is to understand why disease may have taken hold in those crops. This involves a forensic review of the control programme applied.
Ideally, disease control programmes should not just commence in mid-spring, but have a foundation even before the crop is sown. Understanding the disease risk associated with a specific crop or field is fundamental to understanding disease development in the coming spring.
While a lot of this knowledge will be built on past experiences, understanding the risks associated with each crop and our ability to make use of control measures, such as fungicides, still depends on timely application.

The challenge of keeping wheat crops free of septoria increases as sensitivity to SDHIs declines. The challenge of keeping wheat crops free of septoria increases as sensitivity to SDHIs declines.
For example, crops close to the farmyard are likely to be checked regularly and action taken promptly in response to crop development. Crops on an out-farm are likely to be seen less frequently and must therefore be managed to be more resilient to disease development. Similarly, the choice of variety and ability to resist or tolerate disease is equally important.
The fungicide programme must take into account both of these afore-mentioned aspects and be developed and applied using this knowledge. This includes the choice of fungicide and, equally importantly, the fungicide timing. Timing of the fungicide is, in itself, probably one of the most important aspects of disease control.
Fungicides are designed to kill a fungal pathogen and they must be on the crop before the disease develops to impact on crop growth.
Fungicides cannot perform the miracle of bringing a crop back to life if it has already been killed by the disease. That said, chemists in the different chemical companies have developed fungicides to provide a wide spectrum of disease control with extended periods of protection. These improvements have allowed fungicide programmes to be developed to those we have today.
Battles lost
As we review instances where the battle for disease control has been lost, if the aforementioned issues in the control programme have all been ticked, then it becomes a little more complex to ascertain why the disease developed and why the control effort failed.

Isolates of septoria tritica have been found that are less sensitive to SDHI fungicides.The first and easy thought is the possibility that the fungicide did not work. This could be the case for any number of reasons, but the most devastating is the possibility that the fungus that causes the disease was able to overcome the toxic effects of the fungicide. Put another way – the fungus has developed fungicide resistance.
Unfortunately, this is not a new phenomenon for Irish growers. In the modern era, the development of resistance in eyespot to the MBC fungicides, such as Benlate, marked the realisation that fungicide resistance could have major impacts for disease control practises in cereals. This was followed by similar resistances emerging in rhyncho and septoria populations.
However, it was the emergence of resistance to the strobilurin fungicides in Irish septoria and ramularia populations, in particular the appearance of septoria hotspots throughout wheat crops in late June 2002, that really highlighted the consequences of fungicide resistance for Irish growers.
Following the appearance of hotspots in 2002, the Irish septoria population went from being totally susceptible to totally resistant in the space of a single season. Since that time, we have continued to see Irish septoria, and potentially ramularia, populations decline in their susceptibility to the azole fungicides and, more recently, to the SDHIs. Both of these families carried the mantle for the control of these diseases.

Ramularia has also developed resistance to SDHI fungicides on the continent. Ramularia has also developed resistance to SDHI fungicides on the continent.
The question is, therefore, is it inevitable that whatever fungicide we apply that resistance will emerge in time? And if this is the case, is there anything that can be done to mitigate or slow it from occurring or spreading, or should we just throw in the towel?
Why does resistance occur?
Firstly, the development of fungicide resistance is a natural occurrence that, in some form or other, is inevitable. In simple terms, it is evolution at its very best (or very worst as the case may be). When we use fungicides, we create an environment that is pretty much toxic for the fungus to enable us to control the disease.
However, given the vast number of fungal spores that are produced in cereal crops, it is inevitable at some stage, whether in the past, present or future, that a mutant has been or will be produced which can overcome the toxic environment created by a specific fungicide.
If this mutant occurs during a period when we are using a fungicide, it will survive while others are killed, giving it the run of the place in terms of leaf space and nutrients. In this scenario, the mutant will very quickly come to dominate the population.
This is exactly what occurred with the development and spread of strobilurin resistance in septoria and ramularia where virtually total resistance occurred very quickly.
However, in other instances, such as azoles and SDHIs, resistance may not always manifest itself in the same way. Indeed, not all diseases developed resistance to the strobilurins in such a black and white a manner.
This is demonstrated by the lack of complete resistance in net blotch to the strobilurins. Understanding the reasons for these differences can allow us to manage it to a certain extent. However, it is worth noting that what we are doing is trying to manage nature. And the harder we push it to adapt, the quicker it will do just that.

Agar plates used to propagate fungi for testing. The plate in the top left contains a number of different isolates but there is no fungicide in that plate. The two isolates growing in the top right plate have the T79N mutation which shows reduced sensitivity to the SDHIs. However these failed to grow at the higher fungicide concentrations in the bottom two plates. Agar plates used to propagate fungi for testing. The plate in the top left contains a number of different isolates but there is no fungicide in that plate. The two isolates growing in the top right plate have the T79N mutation which shows reduced sensitivity to the SDHIs. However these failed to grow at the higher fungicide concentrations in the bottom two plates.
What causes resistance?
To understand how resistance develops and how we might counteract it, we must firstly understand what a fungicide is doing to the pathogen or disease. Again, in the simplest of terms, it is killing it!
However, there are many means to achieving this same result and different fungicides do this differently. This is what is called the mode of action (MOA) of a fungicide. In the broader sense, we can group fungicides into two categories:
Single-site MOAs. Multi-sites. These reflect how risky a fungicide is to resistance development in the target disease.
In cereals, the most common single-site fungicides belong to the strobilurins (eg Amistar), azoles (eg Proline) and the SDHI (eg Imtrex) groups. These different fungicide groups each have a different MOA, but, as single-site fungicides, they are all extremely specific in their site of activity.
The strobilurins inhibit the ability of the fungus to produce energy by specifically blocking the production of a protein involved. The azoles prevent the fungus from producing its cell walls, which are essential for it to grow, by again blocking a specific protein involved in the process.
The SDHIs also inhibit the fungus from producing its essential energy, but they target a different protein to that targeted by the strobilurins.
Different fungicide actives in the different groups have slightly different affinities or attractions to their target site due to their chemical makeup. This is why some slight differences in activity can be observed between different fungicides from the same group. These are extremely specific interactions which occur between the chemical and the fungus and any little change in either can upset this balance very easily.
In this arrangement, the chemical itself will not change, but differences in how the chemical is delivered, such as the use of an adjuvant, can have an impact. However, it is essential to remember that nature has a built-in mechanism to change and evolve.

A standard micrototre plate which shows fungicide concentration increasing from top to bottom on the left of the plate with different strains being tested across in the vertical columns. The differences in growth from top to bottom reflect the concentration of fungicide needed to slow or prevent growth. A standard micrototre plate which shows fungicide concentration increasing from top to bottom on the left of the plate with different strains being tested across in the vertical columns. The differences in growth from top to bottom reflect the concentration of fungicide needed to slow or prevent growth.
Simple changes – massive
consequences
These changes can be as simple as a single change in the DNA of the fungus. To put this in context, septoria, ramularia and microdochium all have over 30 million sequences of DNA and to overcome the activity of the strobilurins it took just one of these 30 million to change.
This led to a change in the protein targeted, an extremely simple non-dramatic change that did not upset any of these diseases in the slightest. That said, the change was big enough to prevent the strobilurins from entering into the protein and killing the fungus.
The azole fungicides are, arguably, on the other side of the spectrum. They are equally as specific in their MOA, but, in the case of septoria, it has taken some 30 years or so to make an impact on their effectiveness, which came about following multiple changes.
Although individual mutations can confer complete resistance in septoria, it has taken an accumulation of these changes to cause the reduced efficacy in the azoles that we now encounter. Basically, this is a result of a mutation occurring in a strain that already had a mutation or mutations.
What is really intriguing about these accumulations of mutations is that they affect different azoles in a different manner. For some reason, which is not fully understood to date, septoria developed different mutations which impact differently on the efficacy of the main azoles. We now have Opus and Proline at one end and Caramba and Folicur at the other. These are differences that we can utilise and they are discussed later.
Finally, in the case of the SDHIs, we have a unique situation whereby we know and can detect changes in the Irish septoria population that are equivalent to the simple change that resulted in loss of activity to the strobilurins. Indeed, glasshouse experiments demonstrate that strains of septoria with this change (H152R) cannot be controlled by the SDHIs.
However, we also have mutations that confer moderate levels of resistance, on par with what we see to the azoles. The application of SDHIs appears to have selected for these more than the resistant mutants.
Multi-sites – standing the
test of time
While septoria and ramularia have adapted to overcome the single-site fungicides described previously, they have struggled to overcome the multi-site chlorothalonil, to date at least.
This may be due in part to its MOA, which its grouping as a multi-site suggests is likely to have a wider impact on the fungus compared with the single sites described previously.
It should be noted that this does not mean that resistance will never develop. On the contrary, the more we learn about septoria the more it becomes apparent that it has the capacity to greatly adapt and resistance to multi-site would not be beyond its realm.
However, currently, there is no evidence for such an occurrence and multi-sites, such as chlorothalonil, are the cornerstone of cereal production. Up until recently, its inclusion was strongly justified as part of an anti-resistance strategy – for the protection of the azoles and SDHIs. Given the time it took for resistance to emerge for both of these groups, it probably cannot be underestimated how significant a role it played in delaying its onset.
Now that resistance has emerged, the role of multi-sites as an anti-resistance measure remains as important as ever, but they must play an even more important role in disease control. And this is equally true for barley as it is for wheat. Even with new chemistry on the horizon, it must not be understated as to how important chlorothalonil in particular is to cereal production in Ireland.
Programmes that manage
disease and resistance
With resistance to the main fungicides used for cereal disease control now present in many major cereal diseases in Ireland, it is pertinent to question:
A) Will the fungicides provide the disease control needed? B) What does the future for disease control look like?A) As described previously, this very much depends on what mutation takes hold and how quickly it can dominate the population. Clearly, with the strobilurins we no longer get enough control ability to recommend their usage specifically for septoria.
If the SDHI mutation H152R, or equivalent, comes to dominate the population, it is expected that the same fate will occur for the SDHIs. However, until that occurs, they will continue to provide an important element of fungicide control strategies in wheat for septoria, even though their efficacy has clearly been dented by the prevalence of moderately resistant strains.
This question is equally relevant for the azoles where, under Irish conditions, they no longer can be relied upon by themselves to provide sufficient levels of septoria control. But along with the SDHIs they continue to be an integral component for cereal disease control.
The efficacy of both are greatly increased by the addition of a multi-site such as chlorothalonil and to maximise each component, they need to be applied to maximise their protective qualities.
The same case may not be true for ramularia control in barley. In this disease, there are mutations which have caused major impacts on SDHI and azole performance and these have been reported across western Europe.
Teagasc is currently monitoring the Irish ramularia population to determine if this is also the case here, but, given the ability of ramularia to move vast distances, we can expect that if they are not here currently, it will not be long until they are.
Clearly, it is in this situation that the value of chlorothalonil comes into its own, but, as with wheat and septoria, it must be applied at the correct timing. For ramularia control, this corresponds with the final application during booting.
B) What does the future hold for cereal disease control? This is a really difficult question to answer. Resistance is only one aspect that will restrict the availability of useful fungicides.
Changes in the registration process for plant protection products are now starting to affect their availability, with the likely loss of a number of major fungicides that are used across a range of cereal crops in the coming years. While they are currently under the review process, it is difficult to know what the exact outcome of these reviews will be.
Similarly, exciting new fungicides representing new MOAs or new and improved fungicides to current MOAs are already making their way through the registration process.
Irrespective of any of these registration outcomes, the aspect of integrated pest management must be applied and, as described at the start of this article, this must look at all aspects of control and not just the measure that is poured from a can.
It is essential that farmers understand the basics of disease development and the factors which favour and disfavour its progress on the plant.Fungicide resistance can emerge following the tiniest change in the genetic makeup of the fungus. Resistance develops when a mutation that is not controlled can survive when all others are killed by fungicide use.Septoria and ramularia now present major threats in terms of the ability of SDHI actives to control them.
From the end of March through to mid-June every year, we become engaged in a battle between cereal diseases and our ability to control them. This battle takes place at the microscopic level and, in most instances, the scars of war remain unnoticed. Unfortunately, there will always be instances where these scars, in the form of diseased leaves, ears or grain, appear and result in reduced yields.
At research level, we must continue to examine what is happening if the battle is to be won and control of diseases achieved in future seasons.
Dissecting control failures
The first task is to understand why disease may have taken hold in those crops. This involves a forensic review of the control programme applied.
Ideally, disease control programmes should not just commence in mid-spring, but have a foundation even before the crop is sown. Understanding the disease risk associated with a specific crop or field is fundamental to understanding disease development in the coming spring.
While a lot of this knowledge will be built on past experiences, understanding the risks associated with each crop and our ability to make use of control measures, such as fungicides, still depends on timely application.

The challenge of keeping wheat crops free of septoria increases as sensitivity to SDHIs declines. The challenge of keeping wheat crops free of septoria increases as sensitivity to SDHIs declines.
For example, crops close to the farmyard are likely to be checked regularly and action taken promptly in response to crop development. Crops on an out-farm are likely to be seen less frequently and must therefore be managed to be more resilient to disease development. Similarly, the choice of variety and ability to resist or tolerate disease is equally important.
The fungicide programme must take into account both of these afore-mentioned aspects and be developed and applied using this knowledge. This includes the choice of fungicide and, equally importantly, the fungicide timing. Timing of the fungicide is, in itself, probably one of the most important aspects of disease control.
Fungicides are designed to kill a fungal pathogen and they must be on the crop before the disease develops to impact on crop growth.
Fungicides cannot perform the miracle of bringing a crop back to life if it has already been killed by the disease. That said, chemists in the different chemical companies have developed fungicides to provide a wide spectrum of disease control with extended periods of protection. These improvements have allowed fungicide programmes to be developed to those we have today.
Battles lost
As we review instances where the battle for disease control has been lost, if the aforementioned issues in the control programme have all been ticked, then it becomes a little more complex to ascertain why the disease developed and why the control effort failed.

Isolates of septoria tritica have been found that are less sensitive to SDHI fungicides.The first and easy thought is the possibility that the fungicide did not work. This could be the case for any number of reasons, but the most devastating is the possibility that the fungus that causes the disease was able to overcome the toxic effects of the fungicide. Put another way – the fungus has developed fungicide resistance.
Unfortunately, this is not a new phenomenon for Irish growers. In the modern era, the development of resistance in eyespot to the MBC fungicides, such as Benlate, marked the realisation that fungicide resistance could have major impacts for disease control practises in cereals. This was followed by similar resistances emerging in rhyncho and septoria populations.
However, it was the emergence of resistance to the strobilurin fungicides in Irish septoria and ramularia populations, in particular the appearance of septoria hotspots throughout wheat crops in late June 2002, that really highlighted the consequences of fungicide resistance for Irish growers.
Following the appearance of hotspots in 2002, the Irish septoria population went from being totally susceptible to totally resistant in the space of a single season. Since that time, we have continued to see Irish septoria, and potentially ramularia, populations decline in their susceptibility to the azole fungicides and, more recently, to the SDHIs. Both of these families carried the mantle for the control of these diseases.

Ramularia has also developed resistance to SDHI fungicides on the continent. Ramularia has also developed resistance to SDHI fungicides on the continent.
The question is, therefore, is it inevitable that whatever fungicide we apply that resistance will emerge in time? And if this is the case, is there anything that can be done to mitigate or slow it from occurring or spreading, or should we just throw in the towel?
Why does resistance occur?
Firstly, the development of fungicide resistance is a natural occurrence that, in some form or other, is inevitable. In simple terms, it is evolution at its very best (or very worst as the case may be). When we use fungicides, we create an environment that is pretty much toxic for the fungus to enable us to control the disease.
However, given the vast number of fungal spores that are produced in cereal crops, it is inevitable at some stage, whether in the past, present or future, that a mutant has been or will be produced which can overcome the toxic environment created by a specific fungicide.
If this mutant occurs during a period when we are using a fungicide, it will survive while others are killed, giving it the run of the place in terms of leaf space and nutrients. In this scenario, the mutant will very quickly come to dominate the population.
This is exactly what occurred with the development and spread of strobilurin resistance in septoria and ramularia where virtually total resistance occurred very quickly.
However, in other instances, such as azoles and SDHIs, resistance may not always manifest itself in the same way. Indeed, not all diseases developed resistance to the strobilurins in such a black and white a manner.
This is demonstrated by the lack of complete resistance in net blotch to the strobilurins. Understanding the reasons for these differences can allow us to manage it to a certain extent. However, it is worth noting that what we are doing is trying to manage nature. And the harder we push it to adapt, the quicker it will do just that.

Agar plates used to propagate fungi for testing. The plate in the top left contains a number of different isolates but there is no fungicide in that plate. The two isolates growing in the top right plate have the T79N mutation which shows reduced sensitivity to the SDHIs. However these failed to grow at the higher fungicide concentrations in the bottom two plates. Agar plates used to propagate fungi for testing. The plate in the top left contains a number of different isolates but there is no fungicide in that plate. The two isolates growing in the top right plate have the T79N mutation which shows reduced sensitivity to the SDHIs. However these failed to grow at the higher fungicide concentrations in the bottom two plates.
What causes resistance?
To understand how resistance develops and how we might counteract it, we must firstly understand what a fungicide is doing to the pathogen or disease. Again, in the simplest of terms, it is killing it!
However, there are many means to achieving this same result and different fungicides do this differently. This is what is called the mode of action (MOA) of a fungicide. In the broader sense, we can group fungicides into two categories:
Single-site MOAs. Multi-sites. These reflect how risky a fungicide is to resistance development in the target disease.
In cereals, the most common single-site fungicides belong to the strobilurins (eg Amistar), azoles (eg Proline) and the SDHI (eg Imtrex) groups. These different fungicide groups each have a different MOA, but, as single-site fungicides, they are all extremely specific in their site of activity.
The strobilurins inhibit the ability of the fungus to produce energy by specifically blocking the production of a protein involved. The azoles prevent the fungus from producing its cell walls, which are essential for it to grow, by again blocking a specific protein involved in the process.
The SDHIs also inhibit the fungus from producing its essential energy, but they target a different protein to that targeted by the strobilurins.
Different fungicide actives in the different groups have slightly different affinities or attractions to their target site due to their chemical makeup. This is why some slight differences in activity can be observed between different fungicides from the same group. These are extremely specific interactions which occur between the chemical and the fungus and any little change in either can upset this balance very easily.
In this arrangement, the chemical itself will not change, but differences in how the chemical is delivered, such as the use of an adjuvant, can have an impact. However, it is essential to remember that nature has a built-in mechanism to change and evolve.

A standard micrototre plate which shows fungicide concentration increasing from top to bottom on the left of the plate with different strains being tested across in the vertical columns. The differences in growth from top to bottom reflect the concentration of fungicide needed to slow or prevent growth. A standard micrototre plate which shows fungicide concentration increasing from top to bottom on the left of the plate with different strains being tested across in the vertical columns. The differences in growth from top to bottom reflect the concentration of fungicide needed to slow or prevent growth.
Simple changes – massive
consequences
These changes can be as simple as a single change in the DNA of the fungus. To put this in context, septoria, ramularia and microdochium all have over 30 million sequences of DNA and to overcome the activity of the strobilurins it took just one of these 30 million to change.
This led to a change in the protein targeted, an extremely simple non-dramatic change that did not upset any of these diseases in the slightest. That said, the change was big enough to prevent the strobilurins from entering into the protein and killing the fungus.
The azole fungicides are, arguably, on the other side of the spectrum. They are equally as specific in their MOA, but, in the case of septoria, it has taken some 30 years or so to make an impact on their effectiveness, which came about following multiple changes.
Although individual mutations can confer complete resistance in septoria, it has taken an accumulation of these changes to cause the reduced efficacy in the azoles that we now encounter. Basically, this is a result of a mutation occurring in a strain that already had a mutation or mutations.
What is really intriguing about these accumulations of mutations is that they affect different azoles in a different manner. For some reason, which is not fully understood to date, septoria developed different mutations which impact differently on the efficacy of the main azoles. We now have Opus and Proline at one end and Caramba and Folicur at the other. These are differences that we can utilise and they are discussed later.
Finally, in the case of the SDHIs, we have a unique situation whereby we know and can detect changes in the Irish septoria population that are equivalent to the simple change that resulted in loss of activity to the strobilurins. Indeed, glasshouse experiments demonstrate that strains of septoria with this change (H152R) cannot be controlled by the SDHIs.
However, we also have mutations that confer moderate levels of resistance, on par with what we see to the azoles. The application of SDHIs appears to have selected for these more than the resistant mutants.
Multi-sites – standing the
test of time
While septoria and ramularia have adapted to overcome the single-site fungicides described previously, they have struggled to overcome the multi-site chlorothalonil, to date at least.
This may be due in part to its MOA, which its grouping as a multi-site suggests is likely to have a wider impact on the fungus compared with the single sites described previously.
It should be noted that this does not mean that resistance will never develop. On the contrary, the more we learn about septoria the more it becomes apparent that it has the capacity to greatly adapt and resistance to multi-site would not be beyond its realm.
However, currently, there is no evidence for such an occurrence and multi-sites, such as chlorothalonil, are the cornerstone of cereal production. Up until recently, its inclusion was strongly justified as part of an anti-resistance strategy – for the protection of the azoles and SDHIs. Given the time it took for resistance to emerge for both of these groups, it probably cannot be underestimated how significant a role it played in delaying its onset.
Now that resistance has emerged, the role of multi-sites as an anti-resistance measure remains as important as ever, but they must play an even more important role in disease control. And this is equally true for barley as it is for wheat. Even with new chemistry on the horizon, it must not be understated as to how important chlorothalonil in particular is to cereal production in Ireland.
Programmes that manage
disease and resistance
With resistance to the main fungicides used for cereal disease control now present in many major cereal diseases in Ireland, it is pertinent to question:
A) Will the fungicides provide the disease control needed? B) What does the future for disease control look like?A) As described previously, this very much depends on what mutation takes hold and how quickly it can dominate the population. Clearly, with the strobilurins we no longer get enough control ability to recommend their usage specifically for septoria.
If the SDHI mutation H152R, or equivalent, comes to dominate the population, it is expected that the same fate will occur for the SDHIs. However, until that occurs, they will continue to provide an important element of fungicide control strategies in wheat for septoria, even though their efficacy has clearly been dented by the prevalence of moderately resistant strains.
This question is equally relevant for the azoles where, under Irish conditions, they no longer can be relied upon by themselves to provide sufficient levels of septoria control. But along with the SDHIs they continue to be an integral component for cereal disease control.
The efficacy of both are greatly increased by the addition of a multi-site such as chlorothalonil and to maximise each component, they need to be applied to maximise their protective qualities.
The same case may not be true for ramularia control in barley. In this disease, there are mutations which have caused major impacts on SDHI and azole performance and these have been reported across western Europe.
Teagasc is currently monitoring the Irish ramularia population to determine if this is also the case here, but, given the ability of ramularia to move vast distances, we can expect that if they are not here currently, it will not be long until they are.
Clearly, it is in this situation that the value of chlorothalonil comes into its own, but, as with wheat and septoria, it must be applied at the correct timing. For ramularia control, this corresponds with the final application during booting.
B) What does the future hold for cereal disease control? This is a really difficult question to answer. Resistance is only one aspect that will restrict the availability of useful fungicides.
Changes in the registration process for plant protection products are now starting to affect their availability, with the likely loss of a number of major fungicides that are used across a range of cereal crops in the coming years. While they are currently under the review process, it is difficult to know what the exact outcome of these reviews will be.
Similarly, exciting new fungicides representing new MOAs or new and improved fungicides to current MOAs are already making their way through the registration process.
Irrespective of any of these registration outcomes, the aspect of integrated pest management must be applied and, as described at the start of this article, this must look at all aspects of control and not just the measure that is poured from a can.
It is essential that farmers understand the basics of disease development and the factors which favour and disfavour its progress on the plant.Fungicide resistance can emerge following the tiniest change in the genetic makeup of the fungus. Resistance develops when a mutation that is not controlled can survive when all others are killed by fungicide use.Septoria and ramularia now present major threats in terms of the ability of SDHI actives to control them.

SHARING OPTIONS